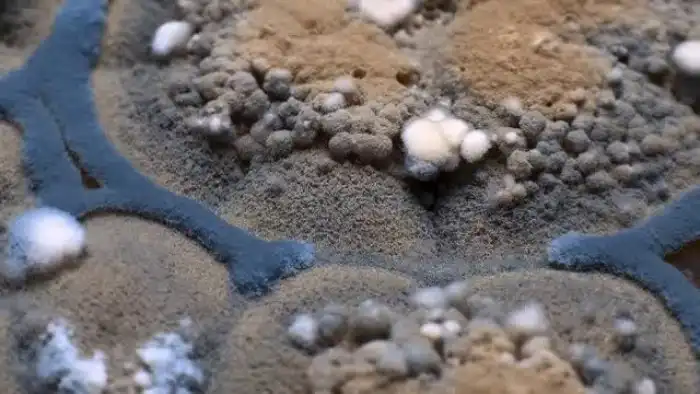
6 фактов о плесени

Плесень – один из самых древних живых организмов на Земле. Она появилась 200 миллионов лет назад и научилась выживать в любых условиях: в радиации, арктических льдах и открытом космосе. Она спасает жизни и способна убить.

Умная плесень
Помните старый эксперимент, где крыса должна найти правильный путь в лабиринте, чтобы заполучить еду. Так вот, как выяснил японский ученый Тошуки Накагаки, плесень справляется с этим заданием не хуже. В 2000 году он провел эксперимент, поместив у входа в лабиринт плесневой гриб «Physarum polycephalum», а на выходе кусочек сахара.
Плесень сразу же пустила «ростки» именно в сторону сахара, споры гриба заполняли собой все пространство в лабиринте, раздваиваясь на каждом перекрестке. Как только какой-нибудь из отростков попадал в тупик, он поворачивал обратно и искал путь в другом направлении. Микроскопическому грибу понадобилось всего 4 часа, чтобы заполнить собой все ходы лабиринта и отыскать верную дорогу к сахару.
Но, что самое интересное, когда у уже прошедшего лабиринт грибного мицелия отщипнули кусок и вновь поставили у входа в лабиринт, положив в конце сахар, – один из ростков безошибочно выбрал самый короткий путь к выходу из лабиринта и сахару, а второй просто «вскарабкался» по стенам лабиринта и пополз по потолку. Таким образом, простая плесень обнаружила не только зачатки памяти, но и способности к нестандартному способу решения задач, что говорит о наличие у гриба интеллекта.

Опасная плесень
Плесень сопровождает нас повсюду, она огромными колониями обитает в ванных, квартирах, вентиляционных шахтах, и что самое неприятное, в наших холодильниках. Поэтому люди привыкли просто ее не замечать. И зря.
Помимо того, что микроскопический грибок способен уничтожать целые здания, он еще и ядовит для человеческого организма. В процессе роста он вырабатывает вещества, которые поражают легкие, кишечник, кожу. Их споры проникают в дыхательные пути и «оседают» внутри нас, открывая дорогу бактериям и вирусам. Аллергия – чуть ли не самое безобидное следствие проживания с плесенью в качестве соседа. Микроскопический грибок способен разрушать структуру ДНК и приводить к раковым заболеваниям.
По словам ученых, плесень и ее яд практически не выводятся из организма. Самой опасной, в данном случае, считается желтая плесень из рода аспергилл, которая «заводится» на молочных продуктах, рыбе и орехах. Она выделяет опасное вещество афлатоксин, которое накапливается в организме и через 10 лет может стать причиной онкологии печени.

Проклятие Тутанхамона
По крайней мере, в двух загадочных смертях, последующих за открытием археологом Говардом Картером нетронутой гробницы Тутанхамона, сегодня винят плесень. Оказалось, что в тканях легких мумии все еще жил плесневый грибок аспергиллус нигер, который может стать смертельным для людей с ослабленным иммунитетом или с поврежденной легочной системой.
Первая жертва «Тутанхамона» — организатор и спонсор раскопок Лорд Карнарвон еще задолго до обнаружения гробницы попал в страшную автомобильную аварию, в которой повредил легкое. Он умер от пневмонии спустя некоторое время после посещения гробницы. Вслед за ним скончался и другой участник раскопок – Артур Мейс, который, по трагичной случайности, был тяжело болен до начала раскопок. Его ослабленная иммунная система стала идеальной средой для проявления смертоносных качеств плесени.

Непобедимая плесень
Одно из основных и самых опасных свойств плесени является ее вездесущность. Микроскопические грибки способны выживать, без преувеличения, в любых условиях. Они прекрасно чувствуют себя среди арктических льдов, на радиоактивном саркофаге 4-го энергоблока Чернобыльской АЭС, и даже в открытом космосе.
Так, в рамках эксперимента «Биориск», который был направлен на исследования влияния условий открытого космоса на живые организмы, три капсулы со спорами плесневых грибов Пенициллум, Аспергилус и Кладоспориум вывели в открытый космос и прикрепили к обшивке орбитальной станции. Результаты были просто ошеломляющие, споры плесневых грибов после полугодового пребывания в открытом космосе не только выжили, но еще и мутировали, став более агрессивными и устойчивыми.
И это еще не рекорд. Исследователи поместили плесень из рода Аспергилус Фумигатус в пробирку с мощным антигрибковым препаратом. Часть колонии выдержала удар. И это несмотря на то, что шанс выжить у плесени в данных условиях был ровно таким же, как у человека, помещенного в концентрированную серную кислоту.

Плесень и антибиотики
Пенициллин – первый в мире антибиотик, спасший жизни сотням тысяч военных во время Второй мировой войны, впервые был выведен британским бактериологом Александром Флемингом в 1928 году из штамма плесневого гриба вида Пенициллум нотатум.
Как и в случае с большинством гениальных открытий, это произошло совершенно случайно. В одной из чашек Петри с бактериями стафилококка, в результате неправильного хранения завелась серо-зеленая плесень. Флеминг с удивлением обнаружил, что не убиваемые колонии стафилококков, унесшие столь много жизней во время Первой мировой, вокруг этой плесени просто растворились. Чудо-лекарство, от которого все раны военных затягивались буквально на глазах, было доработано уже во время Второй мировой. На вручение Нобелевской премии создателям панацеи – Флемингу, Чейну и Флори было сказано: «Для победы в войне пенициллин сделал больше, чем 25 дивизий!».

«Благородная» плесень
Врачи настоятельно рекомендуют – если продукт начал плесневеть, его необходимо выбросить. Простое удаление пораженного участка ни к чему не приведет. Если это мягкие фрукты, хлеб или варенье, то грибница, скорее всего, распространилась на весь продукт.
Но не вся плесень, что на продуктах опасна. Существует и съедобная плесень, с помощью которых человечество вот уже несколько веков изготавливает деликатесные голубые сыры и камамбер.
В начале XV века французский король Карл VI дал жителям деревни Рокфор монопольное право на производство в местных известняковых пещерах сыра с одноименным названием. Технология практически не изменилась с того времени. Каждую головку сыра, изготовленного из овечьего молока, протыкают длинными иглами насквозь, чтобы в него могли попасть споры плесени. А стабильная высокая влажность и низкие температуры обеспечивают быстрый рост грибов.
Другой популярный продукт, получаемый с помощью плесени – французское вино «Шато д’Икем». Для его изготовления виноград поражают «благородной гнилью» — грибком Бодритис Цинереа, из-за которого кожица ягоды утрачивает герметичность, сам плод сморщивается, но содержимое при этом становится более концентрированным. «Шато д’Икем», любимое вино русской аристократии XIX века, сегодня одно из самых дорогих вин мира.